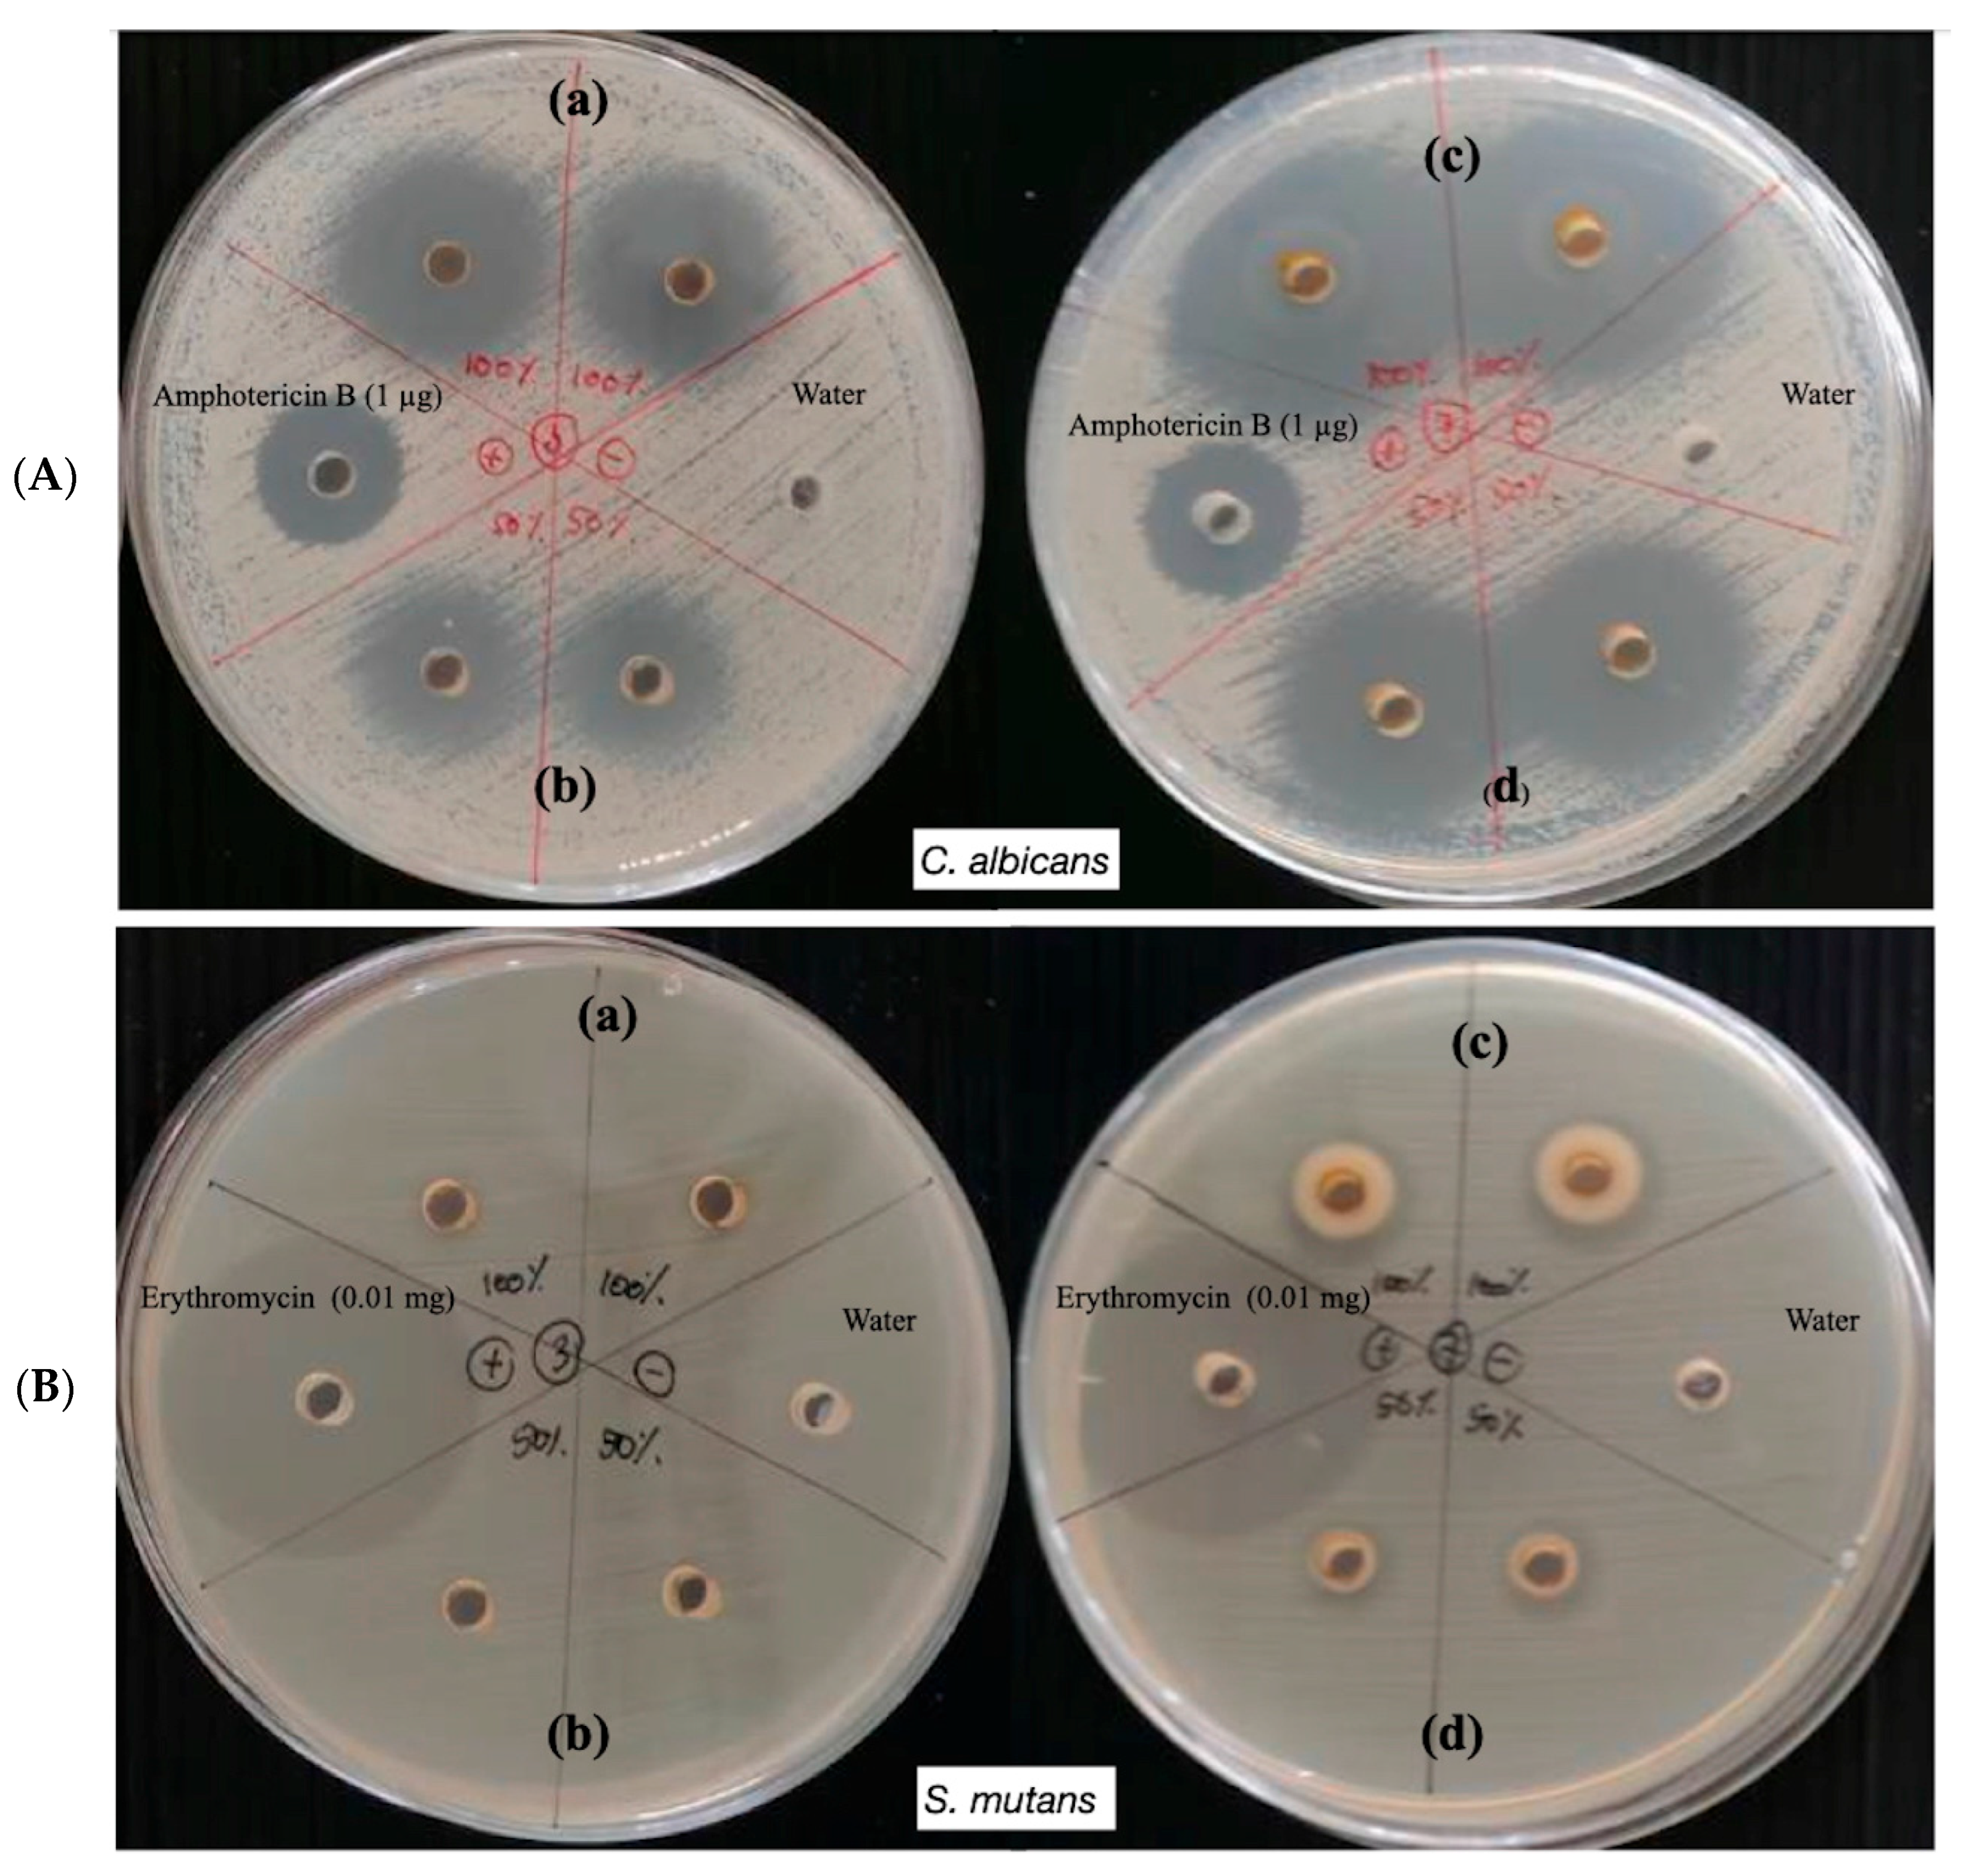
Applbiosci 04 00044 g009 Applbiosci 04 00044 g009

Sustainable Fabrication of Zinc Oxide Nanoparticles Using Assam Green Tea Extract with Promising Oral Antimicrobial Potential
Abstract
1. Introduction
2. Materials and Methods
2.1. Materials
2.2. Preparation of Assam Green Tea Extract
2.3. Determination of Total Phenolic Content
2.4. Determination of Total Flavonoid Content
2.5. DPPH Radicals Scavenging Assay
2.6. Determination of Reducing Power
2.7. Green Synthesis of Zinc Oxide Nanoparticles
2.8. Characterization of Zinc Oxide Nanoparticles
2.9. Stability of Zinc Oxide Nanoparticles
2.10. Antimicrobial Activities of Zinc Oxide Nanoparticles
3. Results and Discussion
3.1. Preparation of Assam Green Tea Extract and Its Biological Properties
3.2. Green Synthesis of Zinc Oxide Nanoparticles
3.2.1. Effects of Reducing Agent Concentration
3.2.2. Effects of Reaction Times and Temperatures
3.3. Characterization of Zinc Oxide Nanoparticles
3.3.1. X-Ray Diffraction (XRD) Spectroscopy
3.3.2. Field Emission Scanning Electron Microscopy (FE-SEM) and Energy Dispersive X-Ray (EDX) Analysis
3.3.3. Fourier Transform Infrared (FT-IR) Spectroscopy
3.4. Stability Study of Zinc Oxide Nanoparticles
3.5. Antimicrobial Activities of Zinc Oxide Nanoparticles
4. Conclusions
Author Contributions
Funding
Data Availability Statement
Acknowledgments
Conflicts of Interest
References
- Shah, M.; Fawcett, D.; Sharma, S.; Tripathy, S.K.; Poinern, G.E.J. Green synthesis of metallic nanoparticles via biological entities. Materials 2015, 8, 7278–7308. [Google Scholar] [CrossRef] [PubMed]
- Mutukwa, D.; Taziwa, R.; Khotseng, L.E. A review of the green synthesis of ZnO nanoparticles utilising Southern African indigenous medicinal plants. Nanomaterials 2022, 12, 3456. [Google Scholar] [CrossRef] [PubMed]
- El-Saadony, M.T.; Fang, G.; Yan, S.; Alkafaas, S.S.; El Nasharty, M.A.; Khedr, S.A.; Hussien, A.M.; Ghosh, S.; Dladla, M.; Elkafas, S.S.; et al. Green synthesis of zinc oxide nanoparticles: Preparation, characterization, and biomedical applications—A review. Int. J. Nanomed. 2024, 19, 12889–12937. [Google Scholar] [CrossRef] [PubMed]
- Rathi, V.H.; Jeice, A.R. Green fabrication of titanium dioxide nanoparticles and their applications in photocatalytic dye degradation and microbial activities. Chem. Phys. Impact 2023, 6, 100197. [Google Scholar] [CrossRef]
- Basnet, P.; Inakhunbi Chanu, T.; Samanta, D.; Chatterjee, S. A review on bio-synthesized zinc oxide nanoparticles using plant extracts as reductants and stabilizing agents. J. Photochem. Photobiol. B 2018, 183, 201–221. [Google Scholar] [CrossRef]
- Villagrán, Z.; Anaya-Esparza, L.M.; Velázquez-Carriles, C.A.; Silva-Jara, J.M.; Ruvalcaba-Gómez, J.M.; Aurora-Vigo, E.F.; Rodríguez-Lafitte, E.; Rodríguez-Barajas, N.; Balderas-León, I.; Martínez-Esquivias, F. Plant-based extracts as reducing, capping, and stabilizing agents for the green synthesis of inorganic nanoparticles. Resources 2024, 13, 70. [Google Scholar] [CrossRef]
- Almoudi, M.M.; Hussein, A.S.; Abu Hassan, M.I.; Mohamad Zain, N. A systematic review on antibacterial activity of zinc against Streptococcus mutans. Saudi Dent. J. 2018, 30, 283–291. [Google Scholar] [CrossRef]
- Djearamane, S.; Xiu, L.-J.; Wong, L.-S.; Rajamani, R.; Bharathi, D.; Kayarohanam, S.; De Cruz, A.E.; Tey, L.-H.; Janakiraman, A.K.; Aminuzzaman, M.; et al. Antifungal properties of zinc oxide nanoparticles on Candida albicans. Coatings 2022, 12, 1864. [Google Scholar] [CrossRef]
- Sirelkhatim, A.; Mahmud, S.; Seeni, A.; Kaus, N.H.M.; Ann, L.C.; Bakhori, S.K.M.; Hasan, H.; Mohamad, D. Review on zinc oxide nanoparticles: Antibacterial activity and toxicity mechanism. Nano-Micro Lett. 2015, 7, 219–242. [Google Scholar] [CrossRef]
- Food and Agriculture Organization of the United Nations (FAO). Global Tea Consumption and Production Driven by Robust Demand in China and India. 2023. Available online: https://www.fao.org/newsroom/detail/global-tea-consumption-and-production-driven-by-robust-demand-in-china-and-india/en (accessed on 12 August 2025).
- Bancirova, M. Comparison of the antioxidant capacity and the antimicrobial activity of black and green tea. Food Res. Int. 2010, 43, 1379–1382. [Google Scholar] [CrossRef]
- Cabrera, C.; Giménez, R.; López, M.C. Determination of tea components with antioxidant activity. J. Agric. Food Chem. 2003, 51, 4427–4435. [Google Scholar] [CrossRef]
- Bansal, S.; Choudhary, S.; Sharma, M.; Kumar, S.S.; Lohan, S.; Bhardwaj, V.; Syan, N.; Jyoti, S. Tea: A native source of antimicrobial agents. Food Res. Int. 2013, 53, 568–584. [Google Scholar] [CrossRef]
- Vuong, Q.V.; Stathopoulos, C.E.; Golding, J.B.; Nguyen, M.H.; Roach, P.D. Optimum conditions for the water extraction of L-theanine from green tea. J. Sep. Sci. 2011, 34, 2468–2474. [Google Scholar] [CrossRef] [PubMed]
- Khan, N.; Mukhtar, H. Tea and health: Studies in humans. Curr. Pharm. Des. 2013, 19, 6141–6147. [Google Scholar] [CrossRef] [PubMed]
- Kawarai, T.; Narisawa, N.; Yoneda, S.; Tsutsumi, Y.; Ishikawa, J.; Hoshino, Y.; Senpuku, H. Inhibition of Streptococcus mutans biofilm formation using extracts from Assam tea compared to green tea. Arch. Oral Biol. 2016, 68, 73–82. [Google Scholar] [CrossRef]
- Neturi, R.S.; Sirisha, R.; Vemuri, S.B.; Siva, S.Y.; Sushma, C.T.; Kumar, P.S. Effects of green tea on Streptococcus mutans counts—A randomised control trial. J. Clin. Diagn. Res. 2014, 8, ZC128–ZC130. [Google Scholar] [CrossRef]
- Subramaniam, P.; Eswara, U.; Maheshwar Reddy, K.R. Effect of different types of tea on Streptococcus mutans: An in vitro study. Indian J. Dent. Res. 2012, 23, 43–48. [Google Scholar] [CrossRef]
- Gharpure, S.; Yadwade, R.; Ankamwar, B. Non-antimicrobial and non-anticancer properties of ZnO nanoparticles biosynthesized using different plant parts of Bixa orellana. ACS Omega 2022, 7, 1914–1933. [Google Scholar] [CrossRef]
- Panyachariwat, N.; Jimtaisong, A.; Saewan, N. Antioxidative potentials of Eleutherine bulbosa bulb and its utilization in topical cosmetic emulsion. Cosmetics 2024, 11, 111. [Google Scholar] [CrossRef]
- Irshad, S.; Salamat, A.; Anjum, A.A.; Sana, S.; Saleem, R.S.; Naheed, A.; Iqbal, A. Green tea leaves mediated ZnO nanoparticles and its antimicrobial activity. Cogent Chem. 2018, 4, 1469207. [Google Scholar] [CrossRef]
- Kołodziejczak-Radzimska, A.; Jesionowski, T. Zinc oxide—From synthesis to application: A review. Materials 2014, 7, 2833–2881. [Google Scholar] [CrossRef] [PubMed]
- Hanif, M.A.; Lee, I.; Akter, J.; Islam, M.A.; Zahid, A.A.S.M.; Sapkota, K.P.; Hahn, J.R. Enhanced photocatalytic and antibacterial performance of ZnO nanoparticles prepared by an efficient thermolysis method. Catalysts 2019, 9, 608. [Google Scholar] [CrossRef]
- Bauer, A.W.; Kirby, W.M.; Sherris, J.C.; Turck, M. Antibiotic susceptibility testing by a standardized single disk method. Am. J. Clin. Pathol. 1966, 45, 493–496. [Google Scholar] [CrossRef]
- Naeini, A.; Khonsravi, A.R.; Chitsaz, M.; Shokri, H.; Kamlnejad, M. Anti-Candida albicans activity of some Iranian plants used in traditional medicine. J. Mycol. Med. 2009, 19, 168–172. [Google Scholar] [CrossRef]
- Velázquez-Hernández, A.M.; Martínez-Gallegos, S.; Albiter, V.; González-Juárez, J.C.; García-Ibarra, C. Synthesis of an antimicrobial chitosan film impregnated with ZnO nanoparticles phytosynthesized with Ruta graveolens plant extract. Microb. Pathog. 2025, 200, 107268. [Google Scholar] [CrossRef]
- Singh, K.; Srichairatanakool, S.; Chewonarin, T.; Brennan, C.S.; Brennan, M.A.; Klangpetch, W.; Utama-ang, N. Manipulation of the phenolic quality of Assam green tea through thermal regulation and utilization of microwave and ultrasonic extraction techniques. Horticulturae 2022, 8, 338. [Google Scholar] [CrossRef]
- Khanongnuch, C.; Unban, K.; Kanpiengjai, A.; Saenjum, C. Recent research advances and ethno-botanical history of Miang, a traditional fermented tea (Camellia sinensis var. assamica) of Northern Thailand. J. Ethn. Foods 2017, 4, 135–141. [Google Scholar] [CrossRef]
- Iravani, S. Green synthesis of metal nanoparticles using plants. Green Chem. 2011, 13, 2638–2650. [Google Scholar] [CrossRef]
- Bekele, B.; Jule, L.T.; Saka, A. The effects of annealing temperature on size, shape, structure and optical properties of synthesized zinc oxide nanoparticles by sol-gel methods. Dig. J. Nanomater. Biostruct. 2021, 16, 471–478. [Google Scholar] [CrossRef]
- Al-Nehia, A.; Al-Odayni, A.-B.; Al-Sharabi, A.; Al-Hammadi, A.; Saeed, W. Pomegranate peel extract-mediated green synthesis of ZnO-NPs: Extract concentration-dependent structure, optical, and antibacterial activity. J. Chem. 2022, 2022, 9647793. [Google Scholar] [CrossRef]
- Muthuvel, A.; Jothibas, M.; Manoharan, C. Effect of chemically synthesis compared to biosynthesized ZnO-NPs using Solanum nigrum leaf extract and their photocatalytic, antibacterial and in-vitro antioxidant activity. J. Environ. Chem. Eng. 2020, 8, 103705. [Google Scholar] [CrossRef]
- Goh, E.G.; Xu, X.; McCormick, P.G. Effect of particle size on the UV absorbance of zinc oxide nanoparticles. Scr. Mater. 2014, 78–79, 49–52. [Google Scholar] [CrossRef]
- Bala, N.; Saha, S.; Chakraborty, M.; Maiti, M.; Das, S.; Basu, R.; Nandy, P. Green synthesis of zinc oxide nanoparticles using Hibiscus sabdariffa leaf extract: Effect of temperature on synthesis, antibacterial activity and anti-diabetic activity. RSC Adv. 2015, 5, 4993–5003. [Google Scholar] [CrossRef]
- Basri, H.H.; Talib, R.A.; Sukor, R.; Othman, S.H.; Arffin, H. Effect of synthesis temperature on the size of ZnO nanoparticles derived from pineapple peel extract and antibacterial activity of ZnO–starch nanocomposite films. Nanomaterials 2020, 10, 1061. [Google Scholar] [CrossRef]
- Sánchez-Pérez, D.M.; Flores-Loyola, E.; Márquez-Guerrero, S.Y.; Galindo-Guzman, M.; Marszalek, J.E. Green synthesis and characterization of ZnO nanoparticles using Larrea tridentata extract and their impact on the in-vitro germination and seedling growth of Capsicum annuum. Sustainability 2023, 15, 3080. [Google Scholar] [CrossRef]
- Batterjee, M.G.; Nabi, A.; Kamli, M.R.; Alzahrani, K.A.; Danish, E.Y.; Malik, M.A. Green hydrothermal synthesis of ZnO nanoparticles for UV-light-induced photocatalytic degradation of ciprofloxacin antibiotic in an aqueous environment. Catalysts 2022, 12, 1347. [Google Scholar] [CrossRef]
- Faisal, S.; Jan, H.; Shah, S.A.; Shah, S.; Khan, A.; Akbar, M.T.; Rizwan, M.; Jan, F.; Wajidullah; Akhtar, N.; et al. Green synthesis of ZnO nanoparticles using aqueous fruit extracts of Myristica fragrans: Their characterizations and biological and environmental applications. ACS Omega 2021, 6, 9709–9722. [Google Scholar] [CrossRef]
- Swain, M.; Mishra, D.; Sahoo, G. A review on green synthesis of ZnO nanoparticles. Discov. Appl. Sci. 2025, 7, 997. [Google Scholar] [CrossRef]
- Ismail, A.M.; Menazea, A.A.; Kabary, H.A.; El-Sherbiny, A.E.; Samy, A. The influence of calcination temperature on structural and antimicrobial characteristics of zinc oxide nanoparticles synthesized by sol-gel method. J. Mol. Struct. 2019, 1196, 332–337. [Google Scholar] [CrossRef]
- Ramesh, M.; Anbuvannan, M.; Viruthagiri, G. Green synthesis of ZnO nanoparticles using Solanum nigrum leaf extract and their antibacterial activity. Spectrochim. Acta Part A 2015, 136, 864–870. [Google Scholar] [CrossRef]
- Zahra, S.; Qaisa, S.; Sheikh, A.; Bukhari, H.; Amin, C.A. Effect of calcination temperature on the structure and morphology of zinc oxide nanoparticles synthesized by base-catalyzed aqueous sol-gel process. Eur. J. Chem. 2022, 13, 162–167. [Google Scholar] [CrossRef]
- Sangeetha, G.; Rajeshwari, S.; Venckatesh, R. Green synthesis of zinc oxide nanoparticles by Aloe barbadensis Miller leaf extract: Structure and optical properties. Mater. Res. Bull. 2011, 46, 2560–2566. [Google Scholar] [CrossRef]
- Jayachandran, A.; Aswathy, T.R.; Nair, A.S. Green synthesis and characterization of zinc oxide nanoparticles using Cayratia pedata leaf extract. Biochem. Biophys. Rep. 2021, 26, 100995. [Google Scholar] [CrossRef] [PubMed]
- Appel, C.; Kuttich, B.; Kraus, T.; Stühn, B. In-situ investigation of temperature induced agglomeration in non-polar magnetic nanoparticle dispersions by small angle X-ray scattering. Nanoscale 2021, 13, 6916–6920. [Google Scholar] [CrossRef]
- Honecker, D.; Bersweiler, M.; Erokhin, S.; Berkov, D.; Chesnel, K.; Venero, D.A.; Qdemat, A.; Disch, S.; Jochum, J.K.; Michels, A.; et al. Using small-angle scattering to guide functional magnetic nanoparticle design. Nanoscale Adv. 2022, 4, 1026–1059. [Google Scholar] [CrossRef]
- Nunes Oliveira, R.; Cordeiro Mancini, M.; Oliveira, F.; Passos, T.; Quilty, B.; Thiré, R.; McGuinness, G. FTIR analysis and quantification of phenols and flavonoids of five commercially available plant extracts used in wound healing. Rev. Mater. 2016, 21, 767–779. [Google Scholar] [CrossRef]
- Thummajitsakul, S.; Silprasit, K. Analysis of FTIR spectra, flavonoid content and anti-tyrosinase activity of extracts and lotion from Garcinia schomburgkiana by multivariate method. Trends Sci. 2022, 19, 5780. [Google Scholar] [CrossRef]
- Hoseinpour, V.; Souri, M.; Ghaemi, N.; Shakeri, A. Optimization of green synthesis of ZnO nanoparticles by Dittrichia graveolens (L.) aqueous extract. Health Biotechnol. Biopharma 2017, 1, 39–49. [Google Scholar] [CrossRef]
- Elumalai, K.; Velmurugan, S.; Ravi, S.; Kathiravan, V.; Adaikala Raj, G. Bio-approach: Plant mediated synthesis of ZnO nanoparticles and their catalytic reduction of methylene blue and antimicrobial activity. Adv. Powder Technol. 2015, 26, 1639–1651. [Google Scholar] [CrossRef]
- Ahmed, S.; Ahmad, M.; Swami, B.L.; Ikram, S. A review on plant extract mediated synthesis of silver nanoparticles for antimicrobial applications: A green expertise. J. Adv. Res. 2016, 7, 17–28. [Google Scholar] [CrossRef]
- Ray, T.R.; Lettiere, B.; de Rutte, J.; Pennathur, S. Quantitative characterization of the colloidal stability of metallic nanoparticles using UV–vis absorbance spectroscopy. Langmuir 2015, 31, 3577–3586. [Google Scholar] [CrossRef]
- Tomaszewska, E.; Soliwoda, K.; Kadziola, K.; Tkacz-Szczesna, B.; Celichowski, G.; Cichomski, M.; Szmaja, W.; Grobelny, J. Detection limits of DLS and UV-vis spectroscopy in characterization of polydisperse nanoparticle colloids. J. Nanomater. 2013, 2013, 313081. [Google Scholar] [CrossRef]
- Macias-Paz, I.U.; Pérez-Hernández, S.; Tavera-Tapia, A.; Luna-Arias, J.P.; Guerra-Cárdenas, J.E.; Reyna-Beltrán, E. Candida albicans, the main opportunistic pathogenic fungus in humans. Rev. Argent. Microbiol. 2023, 55, 189–198. [Google Scholar] [CrossRef] [PubMed]
- Lemos, J.A.; Palmer, S.R.; Zeng, L.; Wen, Z.T.; Kajfasz, J.K.; Freires, I.A.; Abranches, J.; Brady, L.J. The biology of Streptococcus mutans. Microbiol. Spectr. 2019, 7. [Google Scholar] [CrossRef] [PubMed]
- Krzyściak, W.; Jurczak, A.; Kościelniak, D.; Bystrowska, B.; Skalniak, A. The virulence of Streptococcus mutans and the ability to form biofilms. Eur. J. Clin. Microbiol. Infect. Dis. 2014, 33, 499–515. [Google Scholar] [CrossRef]
- Kashyap, B.; Padala, S.R.; Kaur, G.; Kullaa, A. Candida albicans induces oral microbial dysbiosis and promotes oral diseases. Microorganisms 2024, 12, 2138. [Google Scholar] [CrossRef]
- George, D.E.; Shetty, R.; Shetty, P.J.; Gomes, L.A. An in vitro study to compare the effect of different types of tea with chlorhexidine on Streptococcus mutans. J. Clin. Diagn. Res. 2017, 11, ZC05–ZC07. [Google Scholar] [CrossRef]
- Varghese, R.M.; Kumar, A.; Shanmugam, R. Antimicrobial activity of zinc oxide nanoparticles synthesized using Ocimum tenuiflorum and Ocimum gratissimum herbal formulation against oral pathogens. Cureus 2024, 16, e53562. [Google Scholar] [CrossRef]
- Barma, M.D.; Muthupandiyan, I.; Samuel, S.R.; Amaechi, B.T. Inhibition of Streptococcus mutans, antioxidant property and cytotoxicity of novel nano-zinc oxide varnish. Arch. Oral Biol. 2021, 126, 105132. [Google Scholar] [CrossRef]
- Harshitha, V.R.S.; Ilangovar, I.G.K.; Suresh, V.; Pitchiah, S. Synthesis of zinc oxide nanoparticles from Cymodocea serrulata leaf extract and their biological activities. Cureus 2024, 16, e55521. [Google Scholar] [CrossRef]
- Caron, A.J.; Ali, I.J.; Delgado, M.J.; Johnson, D.; Reeks, J.M.; Strzhemechny, Y.M.; McGillivray, S.M. Zinc oxide nanoparticles mediate bacterial toxicity in Mueller-Hinton broth via Zn2+. Front. Microbiol. 2024, 15, 1394078. [Google Scholar] [CrossRef]
- El-Fallal, A.A.; Elfayoumy, R.A.; El-Zahed, M.M. Antibacterial activity of biosynthesized zinc oxide nanoparticles using Kombucha extract. SN Appl. Sci. 2023, 5, 332. [Google Scholar] [CrossRef]
- Cushnie, T.P.T.; Lamb, A.J. Recent advances in understanding the antibacterial properties of flavonoids. Int. J. Antimicrob. Agents 2011, 38, 99–107. [Google Scholar] [CrossRef]
- Daglia, M. Polyphenols as antimicrobial agents. Curr. Opin. Biotechnol. 2012, 23, 174–181. [Google Scholar] [CrossRef] [PubMed]
- Xie, Y.; Yang, W.; Tang, F.; Chen, X.; Ren, L. Antibacterial activities of flavonoids: Structure–activity relationship and mechanism. Curr. Med. Chem. 2015, 22, 132–149. [Google Scholar] [CrossRef]
- Stapleton, P.D.; Shah, S.; Anderson, J.C.; Hara, Y.; Hamilton-Miller, J.M.T.; Taylor, P.W. Modulation of β-lactam resistance in Staphylococcus aureus by catechins and gallates. Int. J. Antimicrob. Agents 2004, 23, 462–467. [Google Scholar] [CrossRef]
- Xu, S.; Kang, A.; Tian, Y.; Li, X.; Qin, S.; Yang, R.; Guo, Y. Plant flavonoids with antimicrobial activity against methicillin-resistant staphylococcus aureus (MRSA). ACS Infect. Dis. 2024, 10, 3086–3097. [Google Scholar] [CrossRef] [PubMed]

| Bioactive Compounds and Biological Activities | Results |
|---|---|
| Total phenolic content (mgGAE/mL extract) | 338.57 ± 3.90 |
| Total flavonoids (µgQE/mL extract) | 123.92 ± 1.34 |
| DPPH (mgAAE/mL extract) | 10.47 ± 0.07 |
| Reducing power (mgAAE/mL extract) | 10.16 ± 0.01 |
| Condition | λMax (nm) | Absorbance |
|---|---|---|
| Week 0 | 399 | 0.859 |
| Week 4 at 4 °C | 407 | 0.851 |
| Week 4 at ambient temperature | 407 | 0.822 |
| Week 4 at 45 °C | 407 | 0.781 |
| Sample Type | Zone of Inhibition (mm) | |
|---|---|---|
| C. albicans | S. mutans | |
| Assam green tea-mediated ZnO NPs (100%) | 19.0 ± 0.0 | 0 |
| Assam green tea-mediated ZnO NPs (50%) | 11.5 ± 0.7 | 0 |
| Concentrated Assam green tea-mediated ZnO NPs (100%) | 27.0 ± 0.0 | 12.0 ± 0.0 |
| Concentrated Assam green tea-mediated ZnO NPs (50%) | 21.5 ± 0.7 | 7.5 ± 0.7 |
| Assam green tea extract | 0 | 0 |
| Amphotericin B (1 µg) | 14.7 ± 0.6 | - |
| Erythromycin (0.01 mg) | - | 29.3 ± 0.6 |
| Water | 0 | 0 |
Disclaimer/Publisher’s Note: The statements, opinions and data contained in all publications are solely those of the individual author(s) and contributor(s) and not of MDPI and/or the editor(s). MDPI and/or the editor(s) disclaim responsibility for any injury to people or property resulting from any ideas, methods, instructions or products referred to in the content. |
© 2025 by the authors. Licensee MDPI, Basel, Switzerland. This article is an open access article distributed under the terms and conditions of the Creative Commons Attribution (CC BY) license (https://creativecommons.org/licenses/by/4.0/).
Share and Cite
Jimtaisong, A.; Saewan, N.; Panyachariwat, N. Sustainable Fabrication of Zinc Oxide Nanoparticles Using Assam Green Tea Extract with Promising Oral Antimicrobial Potential. Appl. Biosci. 2025, 4, 44. https://doi.org/10.3390/applbiosci4030044
Jimtaisong A, Saewan N, Panyachariwat N. Sustainable Fabrication of Zinc Oxide Nanoparticles Using Assam Green Tea Extract with Promising Oral Antimicrobial Potential. Applied Biosciences. 2025; 4(3):44. https://doi.org/10.3390/applbiosci4030044
Chicago/Turabian StyleJimtaisong, Ampa, Nisakorn Saewan, and Nattakan Panyachariwat. 2025. "Sustainable Fabrication of Zinc Oxide Nanoparticles Using Assam Green Tea Extract with Promising Oral Antimicrobial Potential" Applied Biosciences 4, no. 3: 44. https://doi.org/10.3390/applbiosci4030044
APA StyleJimtaisong, A., Saewan, N., & Panyachariwat, N. (2025). Sustainable Fabrication of Zinc Oxide Nanoparticles Using Assam Green Tea Extract with Promising Oral Antimicrobial Potential. Applied Biosciences, 4(3), 44. https://doi.org/10.3390/applbiosci4030044

